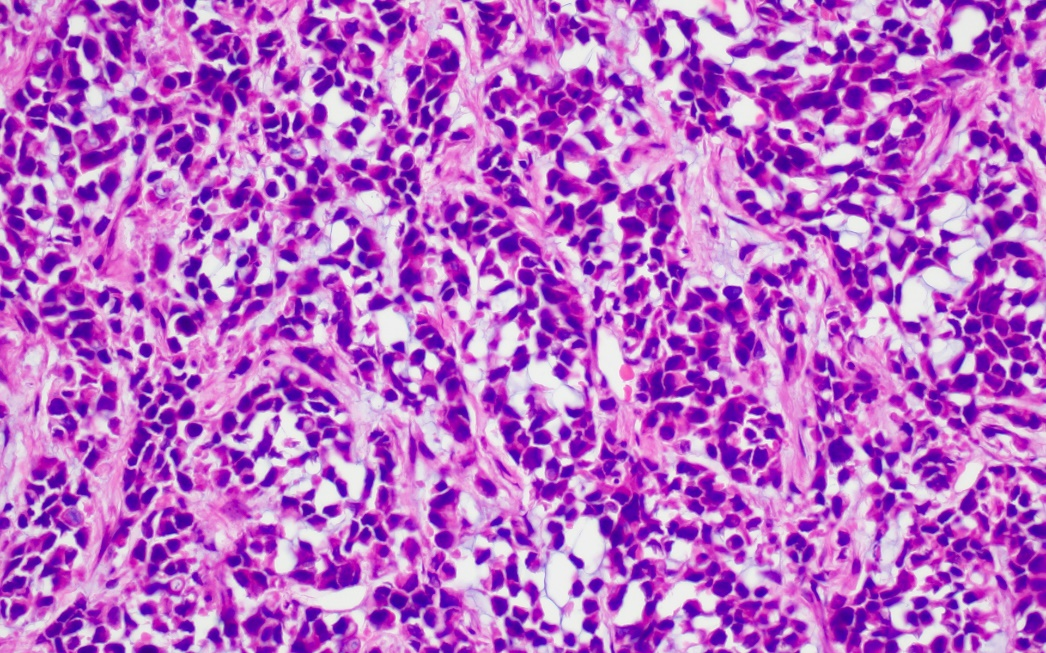
圖片5.png

注冊賬號
部分本平臺服務僅向注冊用戶提供,如果您使用本平臺提供的網絡存儲空間進行視聽、文字等內容的上傳及傳播等,請先根據本協議及其他本平臺規則提示的規則、流程注冊成為注冊用戶,并確保注冊信息的真實性、正確性及完整性,如果上述注冊信息發生變化,您應及時更改。
您應對注冊獲得的本平臺賬號(以下簡稱“賬號”)項下的一切行為承擔全部責任,不得侵犯包括但不限于本平臺在內的任何主體的合法權益。
您理解并同意,您僅享有賬號及賬號項下由本平臺提供的虛擬產品及服務的使用權,賬號及該等虛擬產品及服務的所有權歸本平臺所有(法律法規另有規定的除外)。未經本平臺書面同意,您不得以任何形式處置賬號的使用權(包括但不限于贈與、出借、轉讓、銷售、抵押、繼承、許可他人使用)。如果本平臺發現或者有合理理由認為使用者并非賬號初始注冊人,本平臺有權在不通知您的情況下,暫停或終止向該注冊賬號提供服務,并注銷該賬號。
您應妥善保管賬號信息、賬號密碼以及其他與賬號相關的信息、資料。如因您的原因,造成賬號信息、資料、數據的變動、滅失或財產損失等,您應立即通知本平臺并自行承擔相關法律后果。
本平臺上的內容
本平臺上的內容是指經由本平臺提供的服務,以上傳、張貼或任何其他方式傳送或傳播的任何資訊、資料、文字、軟件、音樂、音頻、照片、圖形、視頻、信息、鏈接或其他資料,無論系公開還是私下傳送(以下簡稱“內容”),內容提供者、上傳者應對其提供、上傳的內容承擔全部責任,如果給本平臺造成損失的,還應向本平臺承擔賠償責任。對于第三方因用戶上傳的內容向本平臺主張權利的,本平臺有權在不事先通知內容提供者、上傳者的情況下直接采取刪除、屏蔽、斷開鏈接等必要措施。
您在本平臺上傳或發布的內容,您保證對其享有合法的著作權或相應授權,本平臺有權展示、散布及推廣前述內容。
為提高您內容曝光量及發布效率,本平臺將額外為您提供全球范圍內的展示和推廣服務,您同意您在本平臺的賬號所發布的全部內容均授權本平臺以您的賬號同步至本平臺運營的全部產品,包括但不限于PC、平板、手機、電視、機頂盒、可穿戴設備等全部客戶端軟件和/或網站。同時,您允許本平臺在同步并展示內容時可自行或委托第三方進行必要的處理(包括但不限于翻譯、匯編、改編等)。您在此確認并同意,本平臺有權自行或委托第三方在與上述內容、本平臺產品及相關服務、本平臺和/或本平臺品牌有關的任何宣傳、推廣和/或研究中以適當的方式開發和使用上述內容(全部或部分)。